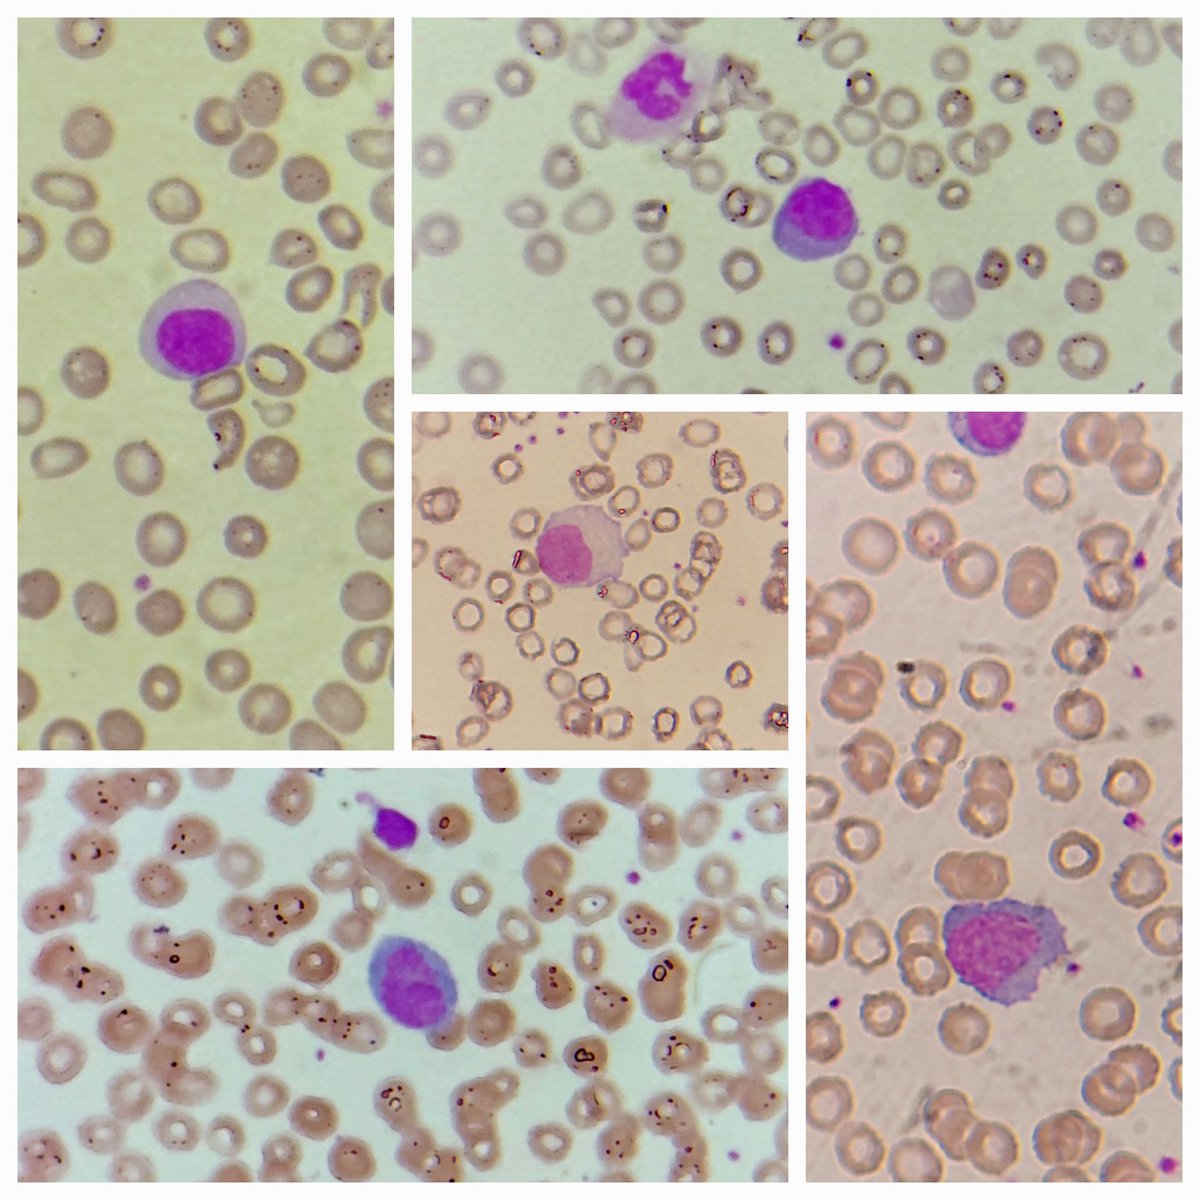
padmapathology1's tweet image. A few reactive and plasmacytoid lymphocytes. History of fever, a couple dengue positive. #hemepath #PathTwitter #IDpath
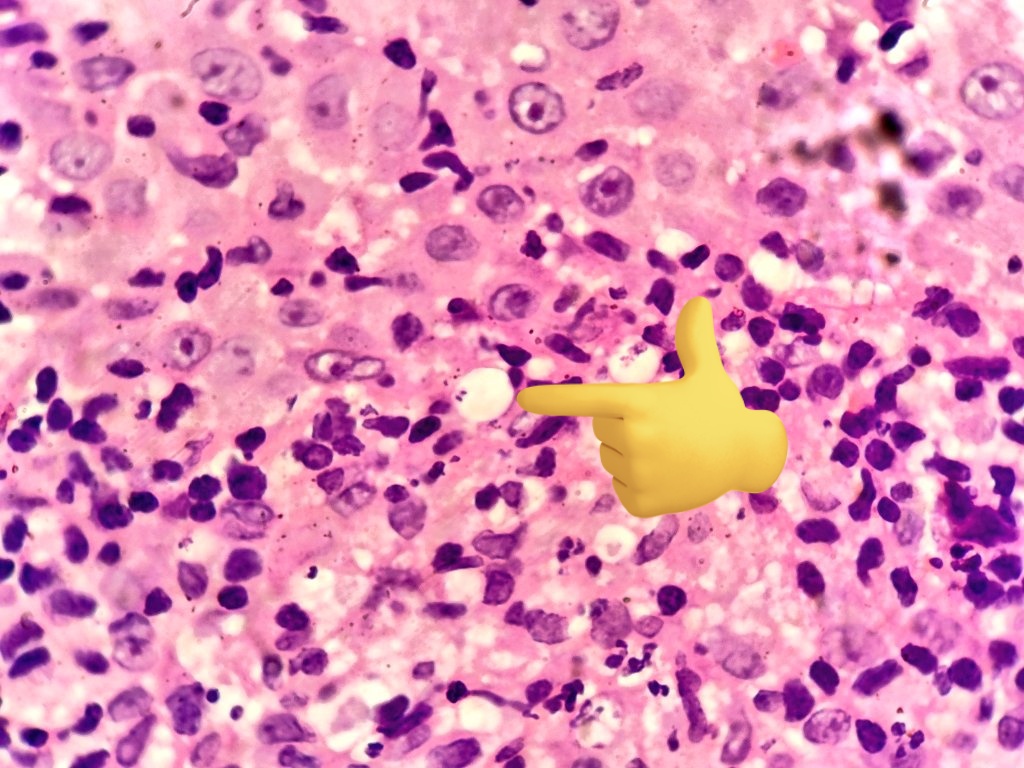
padmapathology1's tweet image. #dermpath 
#IDpath 
#pathtwitter 
Ulcer in the forearm
Diagnosis? 
Please vote in the poll below ⬇️⬇️
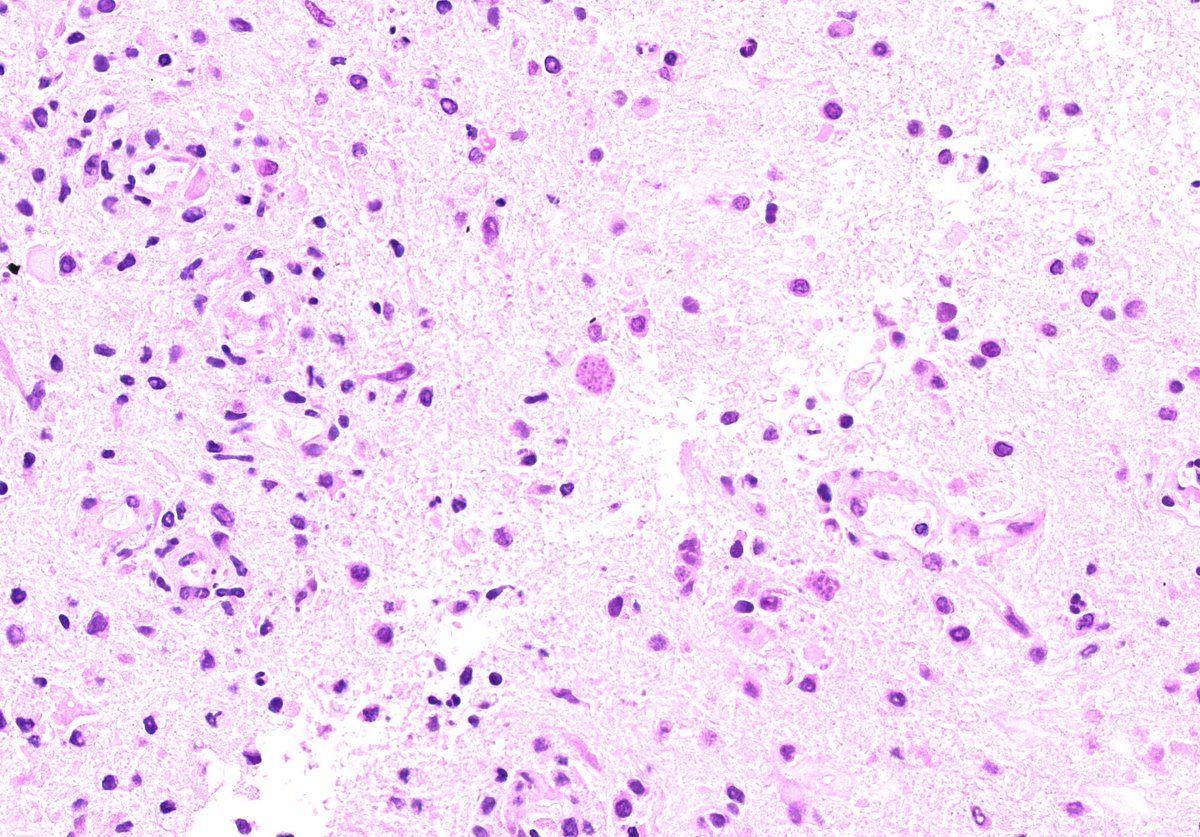
TristanRutland7's tweet image. Brain

(No Hx).

#neuropath #IDpath #Medtwitter #pathresidents #pathtwitter #pathX

#idpath search results
Liver biopsy with Capillariasis infection in an infant #pathology #pedipath
#IDpath #PathTwitter Cryptococcus ✒️India ink preparation ✒️ Budding yeast ✒️ Encapsulated ✒️Cocci of varying sizes ✒️ Immunosuppressed patients #MedicalMicrobiology #medtwitter


A few reactive and plasmacytoid lymphocytes. History of fever, a couple dengue positive. #hemepath #PathTwitter #IDpath

#GIPath #IDPath @BrownPathology A 60 year old man presents with perforated diverticulitis - with a curious finding in the serosal inflammation: Poll in reply.



Incidental finding in penectomy specimen, in the necrotic areas. Features of squamous cell carcinoma seen in preserved focus. Thinking of dead worm. Any definite diagnosis? Please opine. #PathTwitter @ParasiteGal @yro854 @Histopatolomon @DrGeeONE #IDpath #crittersontwitter




Esquistosomiasis rectal👀: 🔸️Caso: ♂️ rectorragia. Colonoscopia➡️ pólipo rectal. 🔸️Agente: Schistosoma (🪱). 3 especies patológicas. 🔸️Contagio contacto agua contaminada💧. 🔸️🔬:huevos🥚calcificados+ parásitos +eosinófilos. 🔸️Tto: 💊Praziquantel. #GIPath #IDPath




More #IDpath (arppress.org/books/book/65): S. aureus is the most frequent cause of infective endocarditis and the left side (esp. mitral valve) is most frequently affected; vegetations can be seen (image). Possible complications: valve leaflet perforation, chordae tendineae rupture.

HIV epidemiology in Australia has changed significantly. In the August issue of #Pathology, Williams et al @TheDohertyInst provide an update on laboratory detection and confirmation of HIV👇 #IDpath #HIV #medtwitter pathologyjournal.rcpa.edu.au/article/S0031-…

20s F with evolving nodules mostly on the extremities of several months duration. Organisms were seen with some difficulty with special stains and retrospectively with H&E. Molecular identification by PCR: Blastomyces spp. #dermpath #pathology #IDpath




Congratulations to Dr. Zane Conrad who completed an Infectious Diseases fellowship at UTSW. #pathology #microbiology #IDpath


Does panfungal PCR have clinical utility in FFPE tissue when no fungal elements are seen on histopathology? See this article in the August issue of #Pathology 👇 pathologyjournal.rcpa.edu.au/article/S0031-… #PathTwitter #PathResidents #microbiology #microbiologylab #IDpath

Not my typical #gupath #gynpath post but an interesting one for trainees! Colon biopsy for GI bleed, clinical concern for IBD. #pathboards


From our newly released series 5 fascicle: Pathology of Non-Helminth Infectious Disease (arppress.org/books/book/65/): T. pallidum infections are characterized by endothelial cell swelling/proliferation and a plasma-cell rich perivascular inflammatory infiltrate. #IDpath

Histopathology and determining the viability of infectious agents - Lucas - Histopathology - Wiley Online Library The great Professor Lucas’ words of wisdom! #IDpath onlinelibrary.wiley.com/doi/full/10.11…
Friday #dermpath special. 😆🔬 Too obvious on low power? Negatron! Go higher not to miss this diagnosis. Chromoblastomycosis #pathology #IDpath 🍄🐛



57. PGY1s, learn this one slide and you will be good to go for 4 major fungal infections. GOLD for boards!! x.com/Janiranavarro/…
fab #IDpath case! when I used to also🔬#GIpath I’d tell trainees: TAKE HOME POINT: don't be afraid to dig in the trash! (don't ignore ulcer debris)
Indeed this is amebic colitis! Uncommon in western world (h/o travel is important). Characteristic flask shaped ulcers, amebic trophozoites often with ingested RBCs. #pathboards
Liver biopsy with Capillariasis infection in an infant #pathology #pedipath
#GIPath #IDPath @BrownPathology A 60 year old man presents with perforated diverticulitis - with a curious finding in the serosal inflammation: Poll in reply.



Incidental finding in penectomy specimen, in the necrotic areas. Features of squamous cell carcinoma seen in preserved focus. Thinking of dead worm. Any definite diagnosis? Please opine. #PathTwitter @ParasiteGal @yro854 @Histopatolomon @DrGeeONE #IDpath #crittersontwitter




❌Lactating Adenoma Proliferation of glands showing secretory/lactational change Lacks granulomas/significant inflammation unless ruptured. #BreastPath #IDPath #Pathology #PathTwitter



\IDPATH-LINEスタンプ販売開始しました!/ 早速Chat GPTの画像生成+CANVA(画像編集)を使い、LINEスタンプを作成しました。 実用性はないです。 👉 購入はこちら store.line.me/stickershop/pr… #LINEスタンプ販売中 #実用性ゼロ #IDPATH #chatgpt画像生成 #canva #chatgpt4o
「夢を追いかける瞬間は、いつもこんなものさ。 落ちるかもしれない不安と、無音の絶望に襲われる」 -Roulette_Jump-part2ショート動画- #IDPATH #ストーリー #AI音楽 ※このBGMはご自身のSNS投稿などで自由に使用OK! ダウンロードはこちら▼ idpath-ai.site/works/
🚗夢を追う瞬間、世界は音を失う── 命ごとBETして飛んだ景色、見たことあるか? 「Roulette_Jumpショート動画公開」 感想くれたら飛んで喜びます。 #IDPATH #物語音楽 #AI音楽 ※このBGMはご自身のSNS投稿などで自由に使用OK! ダウンロードはこちら▼ idpath-ai.site/works/
深海にいた私は――出会えたんだ。 「希望」に。 だから今、私は走り出す。光の道を。 #IDPATH #作業用BGM #物語のある音楽 ぜひ、聴いて~! ※このBGMはご自身のSNS投稿などで自由に使用OK! ダウンロードはこちらから▼ idpath-ai.site
そんな切ない想いが、 ぎゅっと詰まった一曲です。 その強がりの裏に、 隠した本音…ぜひ、感じ取って… あ、やば、ソフィーだ。逃げろー!! -ソフィー- 「ちょっとサンゴ!勝手に何やってるの//」 #IDPATH #ソフィー #ツンデレ #UnspokenFeelings #オリジナル曲
強がるほど、心は泣いてた。 「好き」なんて言葉に意味はないと思ってた。 最後まで聴いたからって、 勘違いしないで。 ……これは、私の弱さじゃない。 ただの、歌よ。 #IDPATH #ソフィー #ツンデレ #UnspokenFeelings #オリジナル曲
心理的安全性の物語版はインスタで公開しているので、ぜひ見てください。 サイコロジカルゲーム↓ instagram.com/p/DHFCeSDTBQP/ #心理的安全性 #職場環境 #IDPATH
「公開前動画」 絵悟悠真です。IDPATHのサイトの紹介動画を作りました。 公開は2025年3/15の土曜日、だいたい夜19時頃に公開。 YOUTUBEで見れますので、見ていただけると幸いです。 youtu.be/VT0DhNVWCr0 #クリエイター #IDPATH #新時代の幕開け
youtube.com
YouTube
IDPATH-サイト紹介-フルバージョン
こんにちは。現在サイト作成中です。 🎬【革命の入り口 – IDPATH】 画像はサイトトップ画像です。 これはただのサイトではない。 土曜日の夜、全てを公開。 サイトでは 💥 AI × 収益化 💥 目標達成 × 自己実現 💥 狂ったコンテンツ × エンタメ を提供。 #IDPATH #クリエイター革命 #新時代の幕開け

初めまして。私は オルフェ。 この曲の題名はまだない。 あなたが感じたままの世界を、この音楽とともに描いてみて。 では、音の波の中で、また逢いましょう。 🎧 フルバージョンはYOUTUBEで🎧 👉 [youtu.be/FiHdp3QDg4k] #オルフェ #idpath #新曲配信 #音楽の旅
#GIPath #IDPath @BrownPathology A 60 year old man presents with perforated diverticulitis - with a curious finding in the serosal inflammation: Poll in reply.



A few reactive and plasmacytoid lymphocytes. History of fever, a couple dengue positive. #hemepath #PathTwitter #IDpath
🥚🐰Happy Easter all! ✏️Short case this week as it holidays. ⚕️Adult, small bowel and stomach #GIpath #IDpath #Pathtwitter #pathresidents




Thank you all for your response. This was Condyloma acuminata. 🔬1️⃣Hyperplastic papillary exophytic squamous epithelium 2️⃣Marked acanthosis 3️⃣Parakeratosis 4️⃣Fibrovascular core 5️⃣Koilocytosis (irregular nuclei, binucleate, perinuclear halo) #gipath #IDpath


Esquistosomiasis rectal👀: 🔸️Caso: ♂️ rectorragia. Colonoscopia➡️ pólipo rectal. 🔸️Agente: Schistosoma (🪱). 3 especies patológicas. 🔸️Contagio contacto agua contaminada💧. 🔸️🔬:huevos🥚calcificados+ parásitos +eosinófilos. 🔸️Tto: 💊Praziquantel. #GIPath #IDPath




#IDpath #PathTwitter Cryptococcus ✒️India ink preparation ✒️ Budding yeast ✒️ Encapsulated ✒️Cocci of varying sizes ✒️ Immunosuppressed patients #MedicalMicrobiology #medtwitter


#IDpath Sequelae of a hail storm in Massachusetts. Made be think of Cryptococcus. I may need to get out more.


20s F with evolving nodules mostly on the extremities of several months duration. Organisms were seen with some difficulty with special stains and retrospectively with H&E. Molecular identification by PCR: Blastomyces spp. #dermpath #pathology #IDpath




現在サイト「IDPATH」を作成中。 ただのサイトではありません。 勉強はつまらない? だから物語形式で学べる場にする想定です 映画や小説を読む感覚でクリエイティブな感性を刺激しながら学べる そんな 「表現者のための灯台のような場所」 を作りたいと思います 近日公開予定 #IDPATH #クリエイター

@AndreMo77438628 moderated our very interesting (albeit skin-crawly at times 🤣) session of #IDpath in surgical #pathology at #USCAP2023 . Thanks to those who came! Looking forward to next year's session! @NYUGSOM_Path @nyulangone




HIV epidemiology in Australia has changed significantly. In the August issue of #Pathology, Williams et al @TheDohertyInst provide an update on laboratory detection and confirmation of HIV👇 #IDpath #HIV #medtwitter pathologyjournal.rcpa.edu.au/article/S0031-…

Congratulations to Dr. Zane Conrad who completed an Infectious Diseases fellowship at UTSW. #pathology #microbiology #IDpath


Something went wrong.
Something went wrong.
United States Trends
- 1. Rickea N/A
- 2. $LOL N/A
- 3. Wisco N/A
- 4. City Connect N/A
- 5. Bmore N/A
- 6. Sparks N/A
- 7. #ENHYPEN_Is_Forever_sevEN N/A
- 8. Red Auerbach N/A
- 9. #FreeManon N/A
- 10. #BOYCOTT_BELIFT_until_Change N/A
- 11. #WeLoveYouManon N/A
- 12. Masters N/A
- 13. Robbo N/A
- 14. Pope N/A
- 15. Patrick Reed N/A
- 16. The Punisher N/A
- 17. US Forest Service N/A
- 18. #HardRockBet N/A
- 19. Selective Service N/A
- 20. Sal Stewart N/A